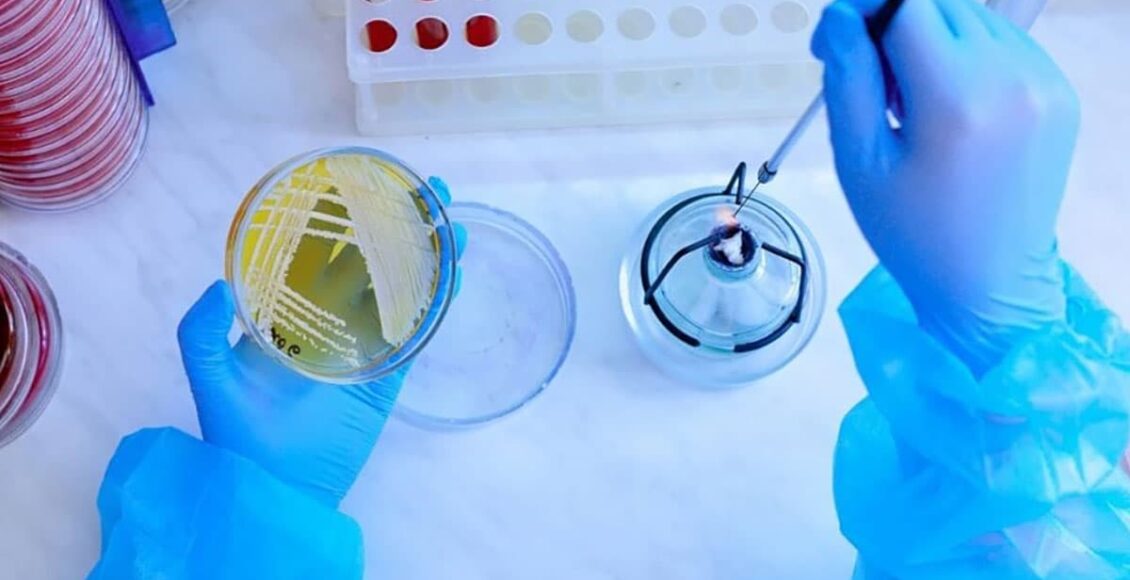
ثبات دما مخصوص ذخیره سازی و نگهداری باکتری ها

مقدمه:
هدف از تهیه این دستورالعمل تدوین روش های صحیح و مناسب ذخیره سازی و نگهداری باکتری ها به روش طولانی و کوتاه مدت، و چگونگی استفاده از آنها برای مقاصد مختلف در بخش میکروب شناسی آزمایشگاه می باشد و در این خصوص نیازمند ثبات دما مخصوص ذخیره سازی و نگهداری باکتری ها نیز هستیم.
روش انجام آزمایش:
نگهداری طولانی مدت (یک سال یا بیشتر):
نگهداری طولانی مدت باکتری ها این امکان را می دهد که نمونه میکروبی، ماه ها و حتی سال ها به صورت زنده باقی بماند. بهترین روش های نگهداری طولانی مدت شامل لیوفیلیزاسیون (Freeze Drying)، نگهداری در فریزر (Ultra Low Freezer) -70◦c یا پایین تر و نگهداری در نیتروژن مایع -۱۹۶◦c
می باشد.
روش های انتخابی و در دسترس:
۱- نگهداری در فریزر (Ultra Low Freezer) -70◦c
- باکتری مورد نظر را روی محیط مغذی مانند پلیت آگار حاوی ۵ %خون گوسفند و در مورد میکروارگانیسم های سخت رشد )پرنیاز (روی محیط شکلات آگار کشت دهید.
- پلیت ها را به مدت ۲۴-۱۸ ساعت در دمای ۱ ± ۳۶ درجه سانتیگراد و در صورت نیاز برای هر باکتری تحت شرایط CO2 انکوبه نمایید.
- بعد از انکوباسیون، خالص بودن و مرفولوژی کلنی ها را بررسی نموده و در صورت نیاز، تست های بیوشیمیایی انجام دهید.
- سپس از باکتری رشد یافته، سوسپانسیون غلیظی در ۱۰۰-۵۰ میلی لیتر از یک محیط محافظت کننده از سرما (Cryoprotective) تهیه نمایید. این محیط برای جلوگیری از تخریب سلول های باکتری در شرایط انجماد مورد استفاده قرار می گیرد.
ثبات دما مخصوص ذخیره سازی و نگهداری باکتری ها در دمای ۸۰- درجه

کاتالوگ دستکاه دیتالاگر مدل DS84

محیط های محافظت کننده از سرما عبارتند از:
- Skim milk
- خون دفیبرینه استریل گوسفند یا خرگوش
- Tryptic Soy Broth (TSB) حاوی گلیسرول با غلظت نهایی ۱۵-۱۰ %
- ۵۰% fetal calf serum in broth
- از سوسپانسیون باکتریایی فوق به مقدار ۱-۵/۰ میلی لیتر در ویال های شیشه ای یا پلاستیکی کوچک استریل توزیع کنید. تعداد کافی ویال ذخیره را برای مصرف یک سال آماده نمایید.
- بر روی ویال ها برچسب حاوی نام (یا کد) سویه و تاریخ تهیه سوسپانسیون را بچسبانید. ویال ها را در فریزر ۷۰- تا۵۰- درجه سانتیگراد قرار داده و تا زمان مورد نیاز در آن ذخیره نمایید. سویه ها را می توان در برودت کمتر از ۵۰- درجه سانتیگراد به مدت طولانی نگهداری کرد.
- در صورت عدم دسترسی به فریزر ۷۰- درجه سانتیگراد می توان سویه ها را در فریزر ۲۰- درجه سانتیگراد نیز نگهداری نمود. در این شرایط توجه به این نکته ضروری است:
- سویه های باکتریایی در این برودت عمر کمتری (حداکثر یک سال) دارند و ممکن است تعداد زیادی از سلول ها از بین بروند. بنابراین توصیه می شود برای اطمینان از زنده بودن سویه ها در فواصل چند ماهه، از کشت ذخیره فریز شده، کشت مجدد بر روی محیط مناسب تهیه شود.
- در صورت نیاز، یک ویال از کشت ذخیره فریز شده را بیرون آورده و محتویات آن را سریعاً زیر آب جاری ولرم ذوب نمایید.
- سوسپانسیون را روی محیط آگار خوندار یا شکلاته (در مورد باکتری های سخت رشد) تلقیح نمایید، به گونه ای که کلنی های ایزوله رشد کنند. پلیت را به مدت ۲۴-۱۸ ساعت در دمای
۱ ± ۳۶ درجه سانتیگراد و در صورت نیاز در شرایط CO2 انکوبه نمایید (ساب کالچر اولیه). قبل از استفاده برای آزمایش، از کشت ذخیره فریز شده، دو بار ساب کالچر انجام دهید. ساب کالچر دوم همان کشت کاری (ژCulture working) می باشد. - پلیت ها را در دمای ۸-۲ درجه سانتیگراد( در مورد ارگانیسم های غیر سخت رشد) یا شرایط مناسب برای هر نوع میکروارگانیسم نگهداری نمایید.
دیتالاگر(ثبات دما) مخصوص نگهداری پلیت ها در دمای ۲_۸ درجه


توجه:
- ویال ذخیره مورد استفاده، بعد از ذوب شدن باید دور انداخته شود و نباید مجدداً فریز گردد.
- قبل از استفاده از سویه رشد یافته روی هر پلیت باید از خالص بودن سویه، اطمینان حاصل نمود.
- از کشت ذخیره فریز شده حداکثر تا ۳ پاساژ پشت سر هم میتوان انجام داد. پس از آن، پلیت باید دور انداخته شود و از یک کشت ذخیره فریز شده دیگر استفاده گردد. پاساژهای پشت سر هم مکرر (بیش از ۳ پاساژ)، احتمال تغییر فنوتیپی سویه ها را افزایش می دهد.
۲- نگهداری در دمای اتاق با کشت در محیط BHIA
- محیط کشت Brain Heart Infusion Agar (BHIA) را با شیب کم در لوله شیشه ای درپیچ دار تهیه نمایید. برای باکتری های سخت رشد، خون تازه یا خون حرارت داده شده، به محیط اضافه نمایید.
- روغن معدنی) یا پارافین مایع( را در اون استریل نمایید.
- میکروارگانیسم مورد نظر را روی سطح محیط کشت دهید و در شرایط مناسب برای هر میکروارگانیسم انکوبه نمایید.
- بعد از اطمینان از وجود رشد کافی، روغن استریل را به مقدار یک میلی لیتر روی سطح محیط بریزید، به گونه ای که سطح شیبدار محیط را بپوشاند.
- لوله ها را با رعایت شرایط ایمنی در دمای اتاق نگهداری کنید.
- در صورت نیاز به کشت مجدد سویه، با لوپ استریل از قسمت زیرین روغن برداشته و روی محیط آگار خوندار یا شکلاته کشت دهید.
- از لوله ذخیره بعد از ۱۲-۶ ماه تجدید کشت نمایید.
۳- نگهداری در دمای اتاق با کشت در محیط TSA
این روش فقط برای باکتری هایی که سخت رشد نیستند، مانند استافیلوکک و انتروباکتریاسه به کار می رود.
- محیط کشت آگار بدون کربوهیدرات را با عمق زیاد در لوله شیشه ای درپیچ دار تهیه کنید. محیط Tryptic Soy Agar (TSA) پیشنهاد می شود.
- باکتری را به صورت کشت عمقی در این محیط تلقیح کنید.
- محیط را به مدت ۲۴-۱۸ ساعت در دمای۱ ± ۳۶ درجه سانتیگراد انکوبه نمایید.
- سپس لوله درپیچ دار را در پارافین مذاب فرو ببرید، که کاملا در لوله را بپوشاند.
- لوله ها را با رعایت شرایط ایمنی در دمای اتاق نگهداری کنید. از لوله ذخیره بعد از ۱۲-۶ ماه تجدید کشت نمایید.
دیتالاگر مخصوص محیط


نگهداری کوتاه مدت (کمتر از یک سال):
۱- کشت در محیط CTA برای نیسریا و استرپتوکک
- محیط کشت Cystine Tryptic agar (CTA) به اضافه یک میلی لیتر سرم استریل اسب را با عمق زیاد در لوله شیشه ای درپیچ دار تهیه کنید .
- سویه نیسریا یا استرپتوکک را به طور عمقی در این محیط کشت دهید.
- محیط را به مدت ۷۲-۲۴ ساعت در دمای ۱ ± ۳۶ درجه سانتیگراد و CO2 پنج درصد انکوبه نمایید.
- سپس لوله درپیچ دار را در پارافین مذاب فرو ببرید، که کاملا درِ لوله را بپوشاند.
- برای نیسریاها لوله را در ۳۵ درجه سانتیگراد نگهداری کنید و هر دو هفته یکبار تجدید کشت نمایید. برای استرپتوکک ها لوله را با رعایت شرایط ایمنی در دمای اتاق نگهداری کرده و هر ماه تجدید کشت کنید.
۲- کشت در محیط Cooked Meat برای باکتری های بی هوازی
- محیط Cooked Meat را در لوله های شیشه ای درپیچ دار تهیه کنید.
- باکتری را در این محیط تلقیح کنید. محیط را به مدت ۷۲-۲۴ ساعت در دمای ۱ ± ۳۶ درجه سانتیگراد انکوبه نمایید.
- لوله ها را با رعایت شرایط ایمنی در دمای اتاق نگهداری کنید.
- هر دو ماه یکبار تجدید کشت نمایید.
۳- کشت در (Tryptic Soy Agar) TSAبرای باکتری های با رشد سریع
- باکتری مورد نظر را در سطح محیط TSA لوله ای درپیچ دار کشت دهید.
- محیط را به مدت ۲۴-۱۸ ساعت در دمای ۱ ± ۳۶ درجه سانتیگراد انکوبه نمایید.
- پس از رشد کامل، لوله را در یخچال نگهداری کنید.
- هر ۴-۲ هفته یکبار تجدید کشت نمایید.
۴- کشت در Sheep blood Agar (آگار خوندار) برای استرپتوکوک ها
- سویه مورد نظر را در سطح محیط آگار خوندار لوله ای درپیچ دار کشت دهیدد.
- محیط را به مدت ۷۲-۲۴ ساعت در دمای ۱ ± ۳۶ درجه سانتیگراد انکوبه نمایید.
- پس از رشد کامل، لوله را در یخچال نگهداری کنید.
- هر دو هفته یکبار تجدید کشت نمایید.
۵- کشت در Chocolate Agar (شکلات آگار) برای مننگوکک و هموفیلوس
- سویه مورد نظر را در سطح محیط شکلات آگار لوله ای یا پلیتی کشت دهید.
- لوله یا پلیت را به مدت ۷۲-۲۴ ساعت در۱ ± ۳۶ درجه سانتیگراد انکوبه کنید.
- لوله یا پلیت را بعد از رشد در حرارت اتاق نگهداری کنید.
- هر دو هفته یکبار تجدید کشت نمایید.
۶- کشت در Chocolate Agar برای گونوکک
- سویه مورد نظر را در سطح محیط شکلات آگار پلیتی یا شیبدار لوله ای کشت دهید.
- لوله یا پلیت را به مدت ۷۲-۲۴ ساعت در ۱ ± ۳۶ درجه سانتیگراد انکوبه کنید.
- پس از این مدت، لوله یا پلیت را مجدداً در این درجه حرارت ( ۱ ± ۳۶ درجه سانتیگراد) نگهداری نمایید.
- هر دو روز یکبار تجدید کشت کنید.